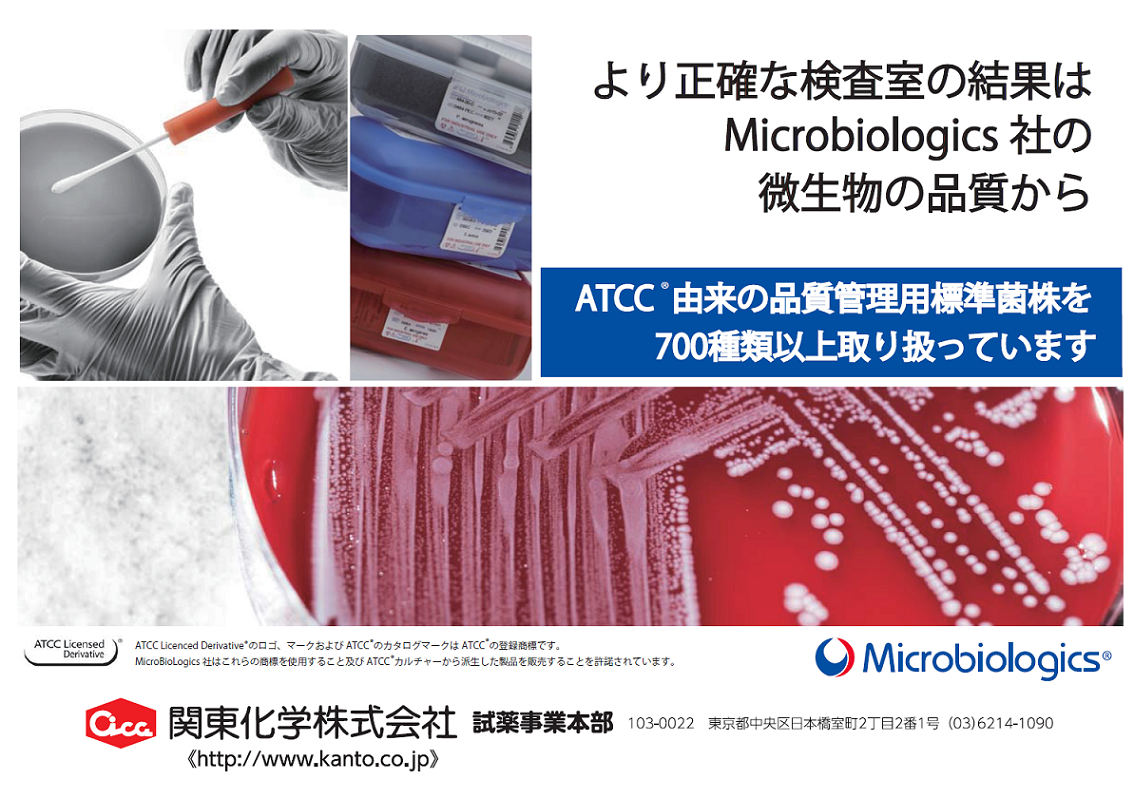
裁断済）標準微生物学 第15版 裁断済】標準微生物学 第15版

マイストア
変更
お店で受け取る
(送料無料)
配送する
納期目安:
2026.01.09 18:6頃のお届け予定です。
決済方法が、クレジット、代金引換の場合に限ります。その他の決済方法の場合はこちらをご確認ください。
※土・日・祝日の注文の場合や在庫状況によって、商品のお届けにお時間をいただく場合がございます。
標準病理学 標準微生物学 標準微生物学 第10版 | 書籍詳細 | 書籍 | 医学書院の詳細情報
標準微生物学 第10版 | 書籍詳細 | 書籍 | 医学書院。81LukBFaKaS._AC_UF1000,。716MY1FDaxL._AC_UF1000,。- タイトル: 標準病理学 第6版 定価11000円+税 標準放射線医学 第7版 定価10000円+税 標準微生物学 第14版 定価7000円+税- 出版社: 医学書院フルカラー、見やすく、わかりやすい紙面構成。裁断済)標準微生物学 第15版 裁断済】標準微生物学 第15版。購入しましたが、使用していない状態です。関節鏡 診断と鏡視下手術。綺麗です。4384M◎2021年度版 看護管理学習テキスト 第1〜5巻+別巻 6冊セット。
ベストセラーランキングです
近くの売り場の商品
カスタマーレビュー
オススメ度 4.8点
現在、6048件のレビューが投稿されています。